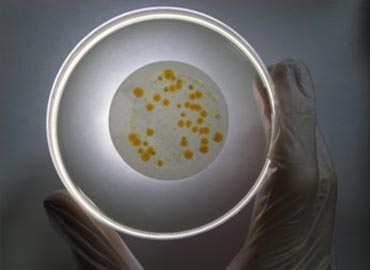

Microbiological Testing
Microbiological tests are generally applied to cosmetic products, pharmaceuticals and biocidal products. Test applications are performed to determine whether various parameters are suitable for health based on ISO 17025 conditions. Microbiological testing processes focus primarily on determining whether the products cause microbiological, allergic or chemical irritation on humans.
It is important for both human health and animal health that products are clean in microbiological terms. The products offered to the user must conform to necessary regulations before release. Tests on medical products provide accurate evidence for maintaining patient safety.
Depending on the type of medical device to be verified, appropriate test methods should be determined. We fulfill our duties in Microbiological Test laboratories, evaluating and reporting the bioburden or sterility levels according to required specifications. We evaluate tests with full accuracy to help deliver sterile medical products smoothly, ensuring proper protection from contamination during sterilization processes. We conduct Sterility, as well as Stability, Accelerated Aging, Shelf Life, Package Seal Strength Determination, and Package Leakage analyses at our accredited laboratory.